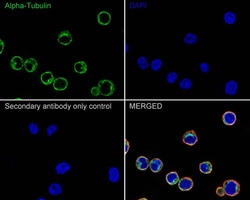
alpha Tubulin Antibody (PSH02-95), Novus Biologicals 100 &mu;L; Unconjugated:Antibodies,

missing translation for 'onlineSavingsMsg'
Learn More
Learn More
alpha Tubulin Antibody (PSH02-95), Novus Biologicals™
Rabbit Monoclonal Antibody
Brand: Novus Biologicals NBP3-33140
This item is not returnable.
View return policy
Description
alpha Tubulin Monoclonal antibody specifically detects alpha Tubulin in Human,Mouse,Rat samples. It is validated for Flow Cytometry,Immunohistochemistry,Western Blot,Immunohistochemistry (Paraffin),Immunocytochemistry/Immunofluorescence
Specifications
| alpha Tubulin | |
| Monoclonal | |
| 1 mg/mL | |
| Western Blot 1:1000-5000, Flow Cytometry 1:1000, Immunohistochemistry, Immunocytochemistry/Immunofluorescence 1:100, Immunohistochemistry-Paraffin 1:1000 | |
| Alpha-tubulin 3, B-ALPHA-1, FLJ25113, hum-a-tub1, hum-a-tub2, LIS3, TUBA3, tublin, tubulin alpha-1A chain, Tubulin alpha-3 chain, Tubulin B-alpha-1, tubulin, alpha 1a, tubulin, alpha 3, tubulin, alpha, brain-specific | |
| Synthetic peptide within Human alpha Tubulin aa 402-451/ 451. (Uniprot: P68363) | |
| 100 μL | |
| Cell Biology, Cell Cycle and Replication, Cytoskeleton Markers, Loading Controls, Neuroscience | |
| 7846 | |
| Store at 4°C short term. Aliquot and store at -20°C long term. Avoid freeze-thaw cycles. | |
| IgG |
| Flow Cytometry, Immunohistochemistry, Western Blot, Immunohistochemistry (Paraffin), Immunocytochemistry/Immunofluorescence | |
| PSH02-95 | |
| Unconjugated | |
| PBS (pH7.4), 0.05% BSA and 40% Glycerol | |
| Rabbit | |
| Protein A purified | |
| RUO | |
| Primary | |
| Human, Mouse, Rat | |
| Purified |
Product Content Correction
Your input is important to us. Please complete this form to provide feedback related to the content on this product.
Product Title
Spot an opportunity for improvement?Share a Content Correction